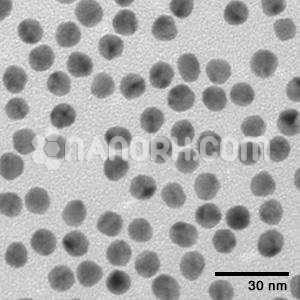
Silver Nanoparticles Ethanol Dispersion Silver Nanoparticles Ethanol Dispersion

Silver Nanoparticles Ethanol Dispersion (Ag, 15nm, Mono Nanopowder, Tawny)
This product is a very stable complex silver solution with ultra-small nano-particles, has a very good anti-bacterial and anti-yellowing properties. The product is for research purpose! (To dilute it to your desired concentration, only add pure water and shake it up!)
| Silver Nanoparticles Ethanol Dispersion | |
| Product No | NRE-22037 |
| CAS No. | 7440-22-4 |
| Formula | Ag |
| Molecular Weight | 107.868 g/mol |
| APS | <15nm (can be customized) |
| Purity | Ag <60 % |
| Color | Tawny |
| Concentration | From 500ppm to 5000ppm |
| Solvent | Ethanol (As Per Requirement) |
| pH | 7±0.5 |
Silver Nanoparticles Ethanol Dispersion
This product does not contain other chemical components. It is safe, non-toxic, and environmental protection. The product is for the purpose of research and development! (To dilute it to your desired concentration, only add pure water and shake it up!)
Cautions:
1. The nanopowder water dispersion should be prevented from sunlight.
2. The product is for research purposes and the user must be a professional person (This person must know how to use this product.)
Silver (Ag) Nanoparticles Aqueous Dispersion Product Features:
1. Broad-spectrum sterilization with long-lasting effect. 2. Rapid onset, no drug resistance. 3. Safety and environmental protection, easy to use.
Ag Aqueous Dispersion, Silver (Ag) Aqueous Dispersion, Ag Water Dispersion, Silver (Ag) Water Dispersion
Silver (Ag) Nanoparticles Aqueous Dispersion Applications:
Various antibacterial finishing for textiles, paper products, leather, and the sponge; anti-bacterial deodorant treatment for all kinds of footwear, toys, and daily necessities; used to implement anti-bacterial deodorizing for a variety of water-based and oil-based paints; widely used in the medical field: microbicides, medical rubber hose, antibacterial gel, lotion, and tablets; soap, cleaning supplies; chemical building materials; plastic products; nano-silver can be added to PE, PP, PC, PET, ABS, and other plastics to achieve antibacterial function.